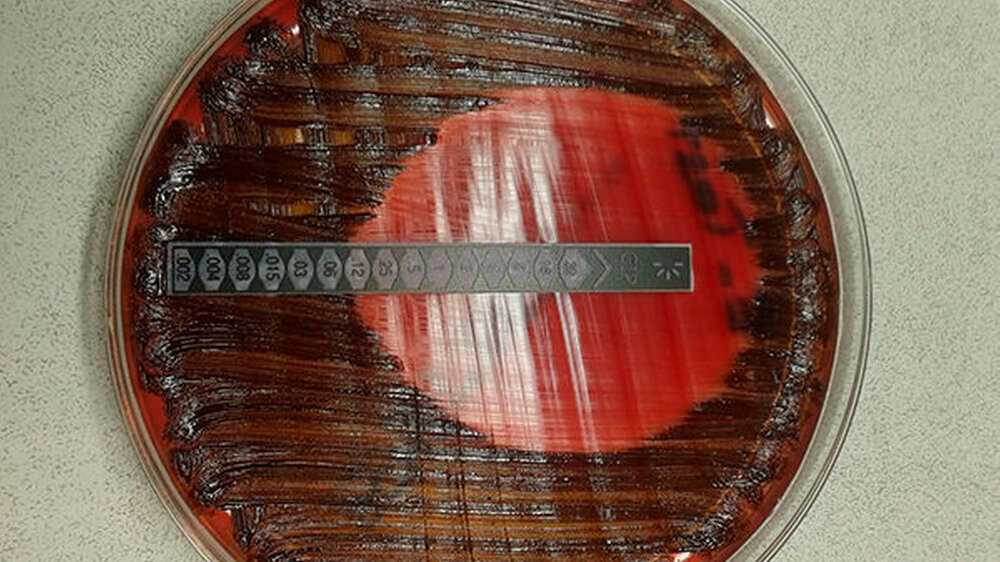

Azithromycin, Metronidazol und Clindamycin: Antibiotikaresistenzen bei Parodontitispatienten
In den letzten Jahren wurden immer häufiger Antibiotikaresistenzen bei oralen Keimen nachgewiesen. Wissenschaftler der Justus-Liebig-Universität Gießen haben nun untersucht, welche Patientenparameter mit Antibiotikaresistenzen assoziiert sind und unter welchen Bedingungen ein Antibiogramm bei Parodontitispatienten indiziert ist.
Grundlage der Untersuchung waren 160 mikrobiologische Tests und die dazugehörigen Antibiogramme von Parodontitispatienten aus dem Zeitraum von 2006 bis 2018, die in der Poliklinik für Parodontologie der Universität Gießen für eine Analyse zur Verfügung standen.
Getestet wurden acht Antibiotika
Für die Tests verwendet wurden Proben aus der jeweils tiefsten parodontalen Tasche eines jeden Sextanten. Die Prüfung mit manuellen und automatisierten Verfahren bezog sich auf mehr als 130 bakterielle Spezies und Pilze. Die Proben wurden anschließend auf Resistenzen gegen acht Antibiotika (Amoxicillin, Ampicillin/Sulbactam, Amoxicillin/Clavulansäure, Doxycyclin, Ciprofloxacin, Clindamycin, Azithromycin, Metronidazol) getestet.
Es erfolgte eine statistische Analyse folgender Parameter: Antibiotikaresistenz, Patientenalter, Geschlecht, Diagnose, Raucherstatus, stationärer Krankenhausaufenthalt und Penicillinallergie.
Insgesamt 48 Bakterienspezies und 5 Pilzarten wurden detektiert
Ergebnisse: Es wurden 48 Bakterienspezies und 5 Pilzarten detektiert. Dabei zeigten nosokomiale Bakterien vermehrt Resistenzen. Insbesondere Azithromycin, Metronidazol und Clindamycin wiesen erhöhte Resistenzraten auf. Es bestand ein Zusammenhang zwischen Antibiotikaresistenz auf die Antibiotikakombination Amoxicillin/Metronidazol und die Patientenparameter "Patientenalter" und "stationärer Krankenhausaufenthalt".
Die übrigen Patientenparameter ergaben keinen Zusammenhang. Durch weiterführende statistische Analysen konnte ein hoher negativer Vorhersagewert für unter 41,5 Jahre alte Parodontitispatienten ermittelt werden. Bei dieser Patientengruppe scheinen Resistenzen gegen die Kombination aus Amoxicillin und Metronidazol eher unwahrscheinlich zu sein. Ähnliches konnte für den Parameter "stationärer Krankenhausaufenthalt" ermittelt werden.
Wenn Patienten anamnestisch keinen "stationären Krankenhausaufenthalt" angaben, lagen ebenfalls signifikant weniger Resistenzen vor.
Dr. Kay-Arne Walther, Dr. Jens Martin Herrmann, Dr. Sabine Gröger, Prof. Dr. Jose Roberto Gonzales, Ghayath Mahfoud, Dr. Wolfgang Falk, Dr. Anita Windhorst, Prof. Dr. Jörg Meyle, Antibiotikaresistenzen bei Parodontitispatienten. Die Untersuchung wurde im Rahmen eines Kurzvortrags auf der diesjährigen Jahrestagung der DG PARO vorgestellt.